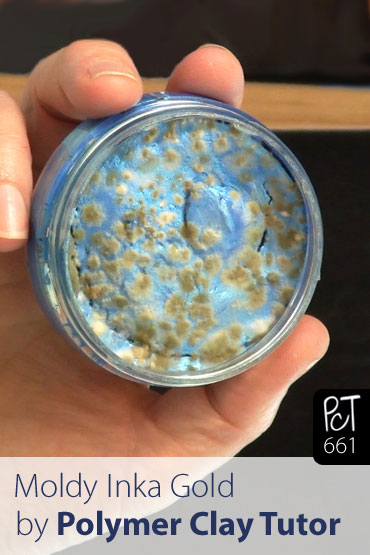
Moldy Inka Gold What To Do? Vid-661
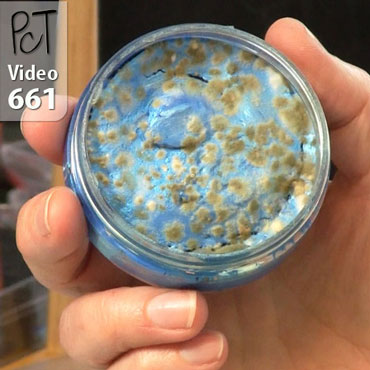
Moldy Inka Gold What To Do? Vid-661

Has Your Inka Gold Metallic Rub Gone All Moldy?
Video #661: Mine did! But don’t fret… here’s why it happens… and more importantly… here is what you can do about it.
More...
IN THIS POST: — inka gold — metallic — rubs — paints — paste — finishes — metal — polish — color rubs — viva décor — moldy — mold — textures — crème — (Topics marked with an asterisk* are discussed in the Comments Section below).
Today we are talking about how to fix moldy Inka Gold Metallic Rub.
A while ago, I did a demonstration on how to use Inka Gold Metallic Paints on Polymer Clay.
We used the Inka Gold on raw and baked polymer clay… and found that it was compatible with polymer, but needed to be added to raw polymer and then baked in order for it to be durable.
Then a viewer said she was having trouble with their Inka Gold going moldy. I checked mine at the time, and it was fine.
However, a few months later, I opened my blue Inka Gold and found that it had indeed gone moldy too!
The mold was not on all the jars… just the Blue, so I did some research to figure out what was wrong and how to fix/avoid it.
Apparently, if you dip your finger into the pot of Inka Gold, you can introduce bacteria from your fingers that you picked up from the environment… and because this product is water based, and has wax and stuff in it, mold can grow on it’s surface… especially in a warm or moist environment.
But… you don’t have to throw your moldy product away! Simply remove the mold with a scraping tool of some sort, and then clean the surface with an antibacterial wipe, or a cloth with disinfectant on it.
The next time you use the rub, just remove a small amount (NOT using your finger), or use a clean cloth so that you aren’t reintroducing new bacteria to the container.
00:00:03 –> 00:00:07 Hi guys, it’s Cindy Lietz, your Polymer Clay Tutor and today in the PcT Test Lab,
00:00:07 –> 00:00:13 we are talking about how to fix moldy Inka Gold Metallic Rub.
00:00:13 –> 00:00:20 Now, a little while ago, I did a demonstration on how to use Inka Gold
00:00:20 –> 00:00:28 paints on polymer clay, and we used them on raw clay and baked clay, and found out
00:00:28 –> 00:00:33 that it was compatible with polymer clay. But you needed to put the Inka Gold on
00:00:33 –> 00:00:36 to raw clay and then bake it.
00:00:36 –> 00:00:40 But one thing that happened over a little bit of time, somebody said they
00:00:40 –> 00:00:44 had a problem with their Inka Gold going moldy, and I said I don’t have a
00:00:44 –> 00:00:45 problem with that.
00:00:45 –> 00:00:49 And then a couple months later, it happened to me,
00:00:49 –> 00:00:57 look it happened. The whole surface went moldy and it wasn’t on all of them either.
00:00:57 –> 00:00:59 This one is just fine,
00:00:59 –> 00:01:03 well I guess this one hasn’t even been opened so this is really… this was opened
00:01:03 –> 00:01:07 before, this one is fine, and this one is fine.
00:01:07 –> 00:01:12 So I had to look into it and find out what the… what the problem was,
00:01:12 –> 00:01:18 and apparently, if you dip your finger into your Inka Gold, you can get some
00:01:18 –> 00:01:23 bacteria from you know, wherever, the air, and your fingers, and the surfaces, and
00:01:23 –> 00:01:30 stuff. And because this is a… this product has water and waxes and things in it, it
00:01:30 –> 00:01:35 can grow the bacteria right on top especially if it gets moisture in your
00:01:35 –> 00:01:38 air or it gets warm and that kind of thing.
00:01:38 –> 00:01:42 So apparently, you don’t have to throw this away you can actually fix it. And
00:01:42 –> 00:01:45 I’m just going to show you how to do that which is good because Inka Gold
00:01:45 –> 00:01:50 is a beautiful product and you don’t want it to get wrecked, and you don’t
00:01:50 –> 00:01:55 want to… you want to be able to keep it and use it. So what you need to do is
00:01:55 –> 00:02:00 you need to get some sort of disinfectant wipe, whether you use…
00:02:00 –> 00:02:07 I have a Lysol Hydrogen Peroxide that I use in the studio but you could use any
00:02:07 –> 00:02:12 of the disinfectant wipes or you could use a disinfectant cleaner or bleach or
00:02:12 –> 00:02:14 something on a cloth.
00:02:14 –> 00:02:18 And what you need to do then is wipe away…
00:02:18 –> 00:02:26 First, what I’m going to do is I’m going to clean a little scoop thing here and
00:02:26 –> 00:02:33 then I’m going to just try to scrape off any of the obvious sections of mold and
00:02:33 –> 00:02:41 get rid of that, and then we’re going to wipe down the top surface with with this
00:02:41 –> 00:02:47 disinfectant wipe, then from then on I will no longer dip my finger into there.
00:02:47 –> 00:02:54 I will use a little scoop like this or little palette knife or something, and
00:02:54 –> 00:02:57 get the paint out onto a surface before I use it.
00:02:57 –> 00:03:05 Another option is to… Another option would be to use a soft cloth that was
00:03:05 –> 00:03:18 clean and put that on the… do that on the surface and we’ll just clean this up.
00:03:18 –> 00:03:27 It’s going to take me a minute or so, just a second here, and then what I’ll do
00:03:27 –> 00:03:34 is wipe this down with this cloth. Now, isn’t that good to know? Because you don’t want
00:03:34 –> 00:03:40 to be wrecking or losing any of your expensive ingredients, but from now on
00:03:40 –> 00:03:46 I’m just going to keep it bacteria-free by just using a clean cloth or a
00:03:46 –> 00:03:47 little scoop in there.
00:03:47 –> 00:03:54 Alright, so that’s how you fix your Moldy Inka Gold,
00:03:54 –> 00:04:01 we’ll see you next time and don’t forget, if you have any questions or comments,
00:04:01 –> 00:04:04 leave those in the comments section below and do let us know if you like
00:04:04 –> 00:04:11 this video. And if you have other questions about polymer clay that you
00:04:11 –> 00:04:15 need answers to, there’s a pretty good chance that we’ve already done a video on it
00:04:15 –> 00:04:18 so make sure to check out our past videos and see if you can find the
00:04:18 –> 00:04:22 answer there. And if not, leave your suggestions in the comment section below.
00:04:22 –> 00:04:24 Alright, we’ll see you next time bye for now.
Our goal is to translate these videos into as many languages as possible. If you are interested in helping with this initiative, then please do contact us and we will figure out a way to make it worth your while :)
Resource Links:
- Related Video: Tips for Using Inka Gold On Polymer Clay
- Related Video: Using Gilder’s Paste on Your Polymer Clay
- Related Article: 5 Creative Tips For Using Acrylic Craft Paints
- Related Video: Make Your Own Crackle Paint
- Amazon: Inka Gold Metallic Rub **
Resources marked with a double ** asterisk are affiliate links. If you click on them and decide to buy something, we may receive some compensation. This does not affect the price you pay in any way. What it does do, however, is helps us to continue providing free videos for you, here at the PcT website. Using our links to purchase your tools and supplies, is always greatly appreciated.
Sponsored Ads & Special Promotions

Shareable Images

To share this full blog post anywhere on the web that allows links in comments, here's a shortened url to copy and paste...
>> https://mypct.ca/v661 <<
Want to chat about today’s post? That’s what the comment section below is for. Scroll Down… We’d love to hear from you!
Or... if you would like to request a topic for a future post, here is the link to do that… PcT Suggestion Box

I’m not sure if this is the right place to post this, but here it goes: I’ve seen a few people saying that you could emulate liquid polymer clay by just using water or olive oil and the clay of your choice. Is that really an option? Because where I live I can’t seem to find tls/liquid policlay anywhere, and an alternative for frosting donuts and that sort of thing would be more than welcome.
I was wondering if you could make a video regarding that subject.
Cheers,
Julia
Hi Julia, this place is just fine for your question, though posting a question like this would be best suited on a post onthe same subject, like ‘liquid clay’ or something. (You can find relevant posts easily by using the search box at the top of the page.)
Any way, as far as making your own liquid clay… I would have to test that, but making a translucent version that was as strong as the real stuff may be more complicated than just diluting clay with oil. For frosting however, there would be such a high ratio of clay to oil, that you can definitely just add a few drops of mineral oil to some clay to make a decent quality of frosting/icing. I just would not expect to get a nice clear shiny replacement for TLS if you planned to use in a lot of other techniques.
I love the shoe polish smell of Gilders Paste. Inc gold is easier to find locally, I have seen it at Hobby Lobby and I always have to order Gilders paste from a web site. You can use gilder paste on unbaked clay and some people use it in Mokume Gane between sheets of translucent. It does melt during the baking process because it is wax based but that can give you a cool look. Gilders paste does dry out but Cindy has a tut on making it come back to life.
Anna
Cool info Anna!
Hi Cindy,
You mentioned to put inka gold on unbaked clay……what about gilders paste do you put it on baked or unbaked clay? Your videos are wonderful I learn so much from them….I just purchased both inka gold and gilders paste and didn’t know how to use them, but thanks to you I know now how to use them…..you’re the best.
Hi Kathay, type the words Gilders Paste into the search box and you will see that I have already done a video on how to use it on polymer clay.
This happened to me! Good to know how to fix it., and how to prevent it from happening next time. I haven’t opened my jar in forever because I know it’s so moldy on the inside. Will have to use this tip, thanks!
Wat is the difference between Gilders Paste and Inca Gold? They look really similar. Gilders paste definitely has a shoe polish smell.
Ok, so call me crazy but I love that waxy shoe polish smell. :-). It reminds me of all the years I saw (and smelled) my dad polish his army boots. I opened up one of my gilders tins one time and closed my eyes and took a deep breath, unaware that my husband was watching me. He goes “are you sniffing your gilders paste again?” I just smiled at him and said “yes……yes I am.” :-)
You’re funny Karen!
Hi Anna, sorry to have missed this… Inca Gold is more like a whipped metallic paint. It is water based rather than solvent based like the Gilder’s Paste is but I do believe it also has wax in it, like the GP. There really isn’t much smell at all. The two are similar but different. Try them both and see what you think.
Very interesting information Cindy. Kind of like cheese, you can always scrape a little mold off and the rest is still consumable. Of course we are not eating Inka Gold, LOL, also a good idea to keep all of this stuff up and away from little hands as they might look at it as candy or sweets.
Great info. Thank you! These are kind of pricey to have to toss, so glad to know there is a fix if this happens.